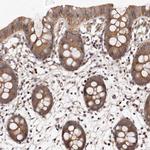
PANK4 Antibody in Immunohistochemistry (IHC)

Search
Invitrogen
PANK4 Polyclonal Antibody
{{$productOrderCtrl.translations['antibody.pdp.commerceCard.promotion.promotions']}}
{{$productOrderCtrl.translations['antibody.pdp.commerceCard.promotion.viewpromo']}}
{{$productOrderCtrl.translations['antibody.pdp.commerceCard.promotion.promocode']}}: {{promo.promoCode}} {{promo.promoTitle}} {{promo.promoDescription}}. {{$productOrderCtrl.translations['antibody.pdp.commerceCard.promotion.learnmore']}}
产品信息
PA5-55736
种属反应
宿主/亚型
分类
类型
抗原
偶联物
形式
浓度
规格
纯化类型
保存液
内含物
保存条件
运输条件
RRID
产品详细信息
Immunogen sequence: ALDGVVKRAV ASQPDSVDAA ERAEKFRQKY WNKLQTLRQQ PFAYGTLTVR SLLDTREHCL NEFNFPDPYS KVKQRENGVA LRCFPGVVRS LDALGWEERQ LALVKGLLAG NVFDWGAKAV SAVLESDPYF
Highest antigen sequence identity to the following orthologs: Mouse - 89%, Rat - 91%.
靶标信息
This gene encodes a protein belonging to the pantothenate kinase family. Pantothenate kinase is a key regulatory enzyme in the biosynthesis of coenzyme A (CoA) in bacteria and mammalian cells. It catalyzes the first committed step in the universal biosynthetic pathway leading to CoA and is itself subject to regulation through feedback inhibition by CoA. This family member is most abundant in muscle but is expressed in all tissues.
仅用于科研。不用于诊断过程。未经明确授权不得转售。
篇参考文献 (0)
生物信息学
蛋白别名: 4'-phosphopantetheine phosphatase; DKFZp547M242; FLJ10782; hPanK4; Inactive pantothenic acid kinase 4; pantothenic acid kinase 4; unnamed protein product
基因别名: CTRCT49; PANK4
UniProt ID: (Human) Q9NVE7
Entrez Gene ID: (Human) 55229